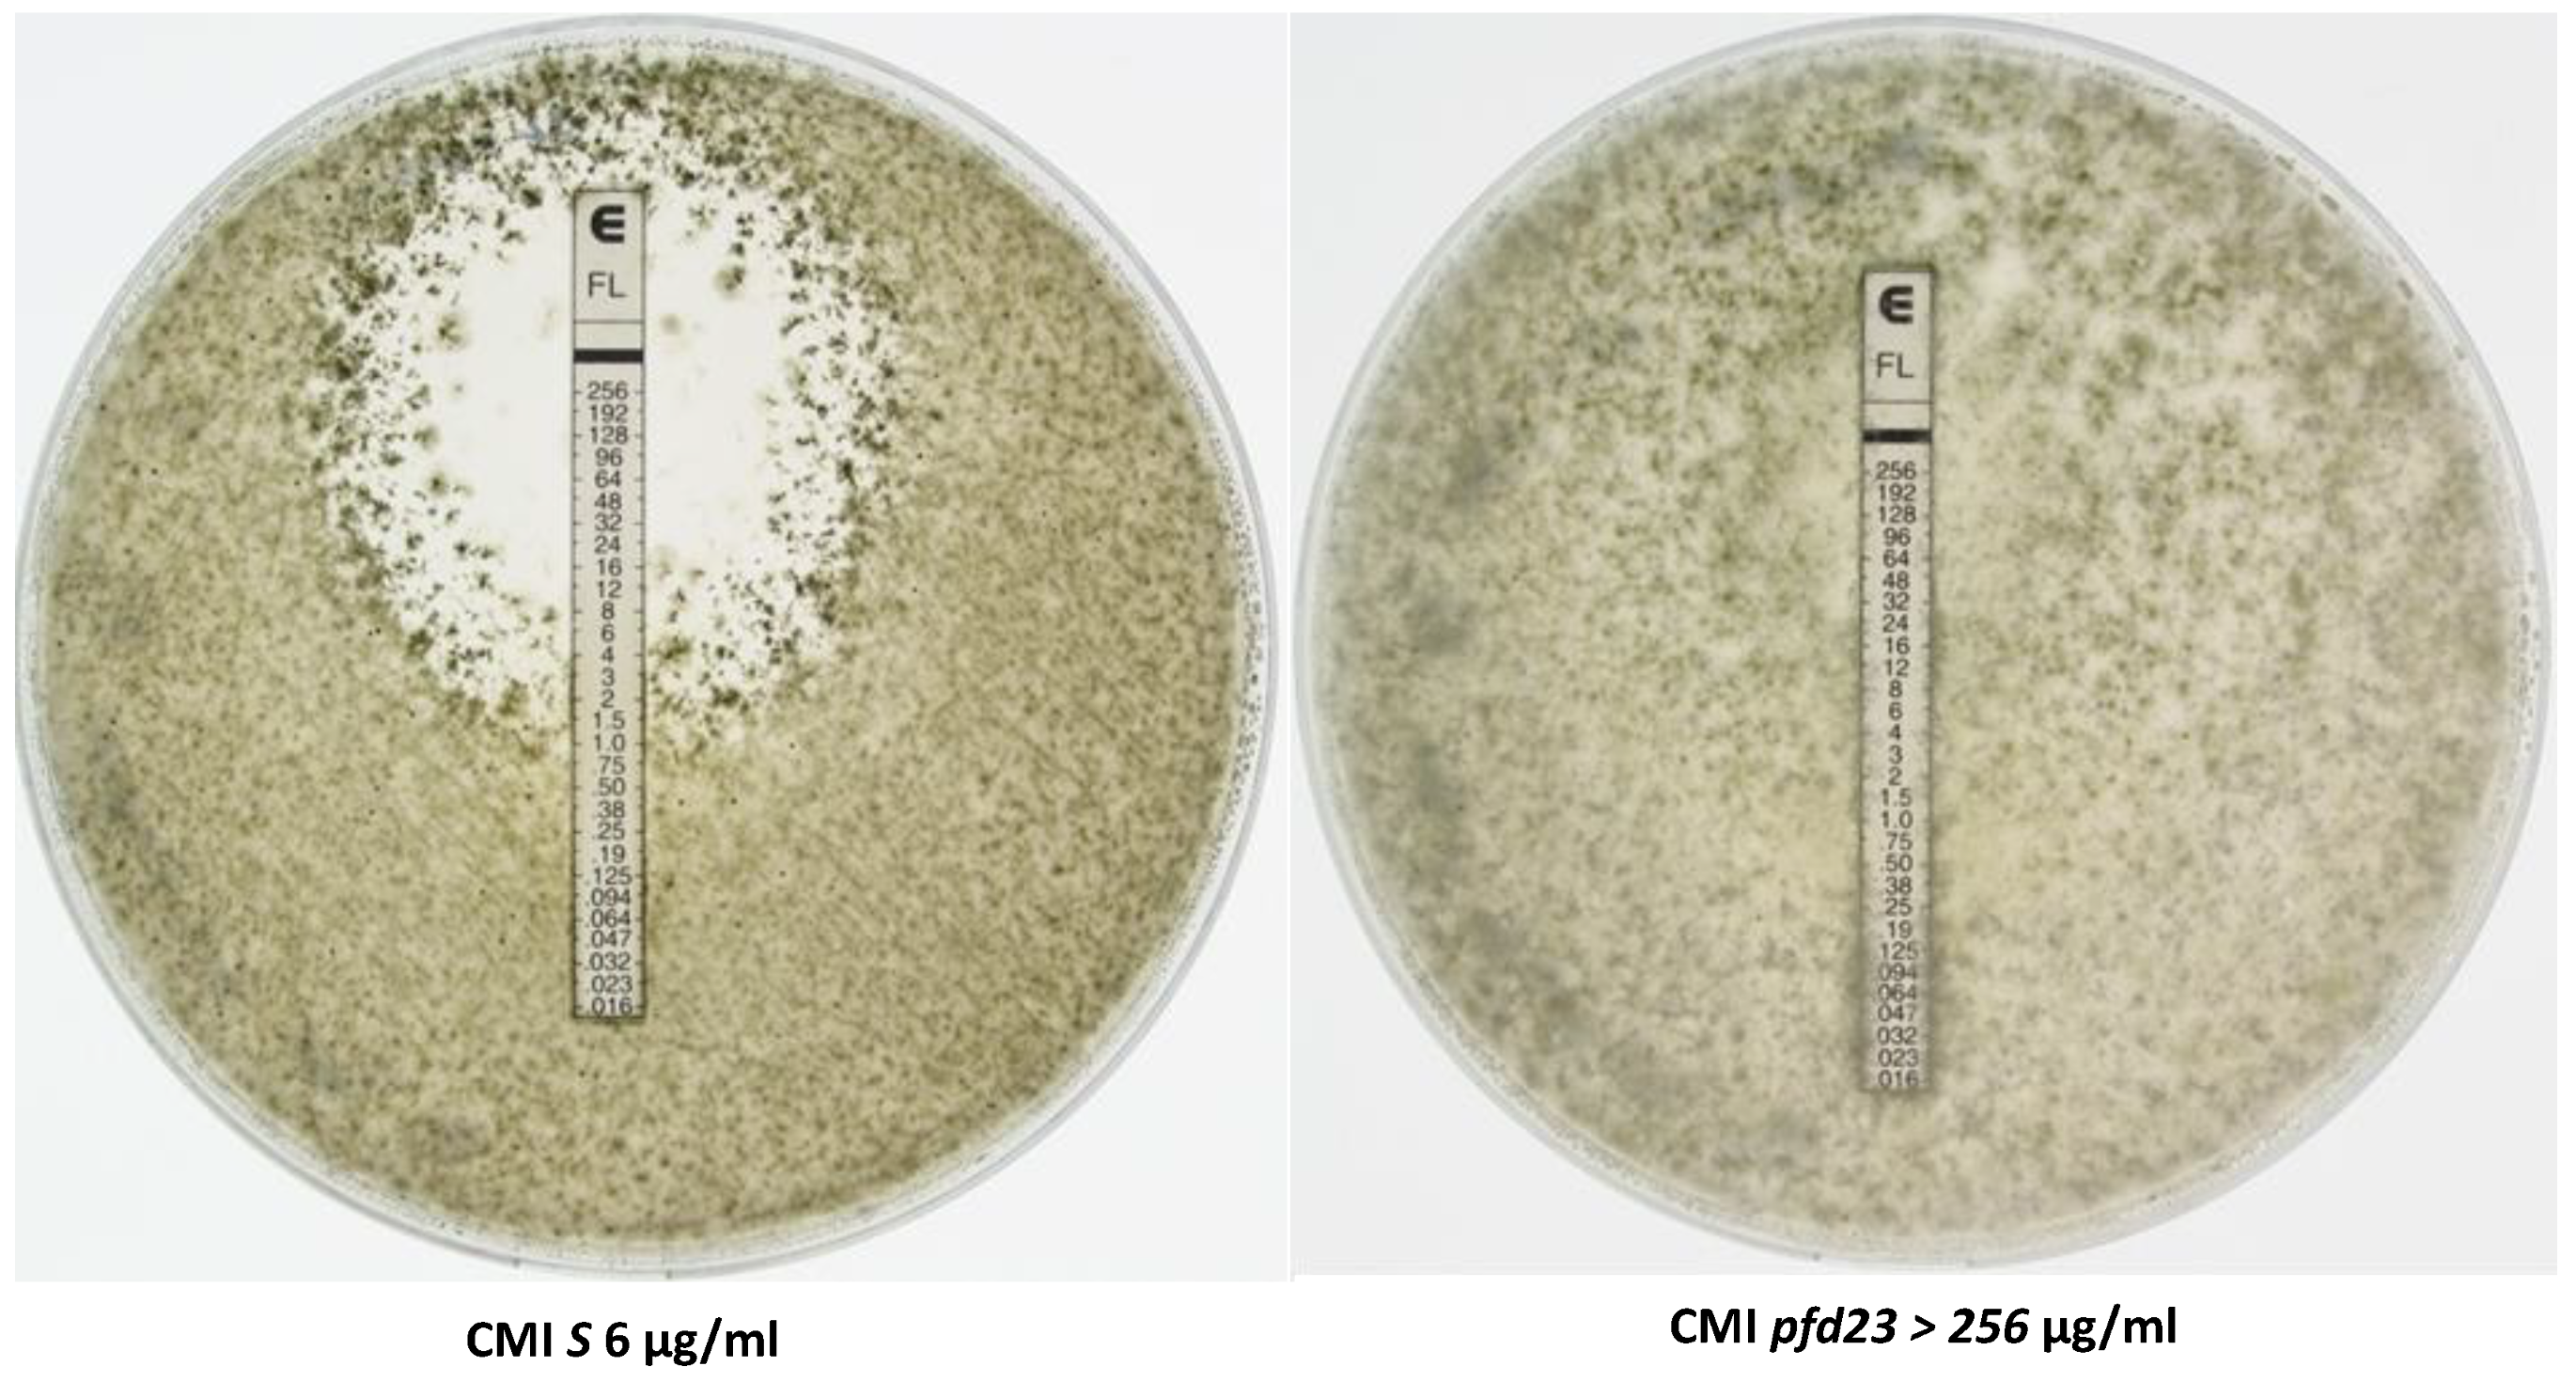
Jof 10 00079 g006

Mutations in Podospora anserina MCM1 and VelC Trigger Spontaneous Development of Barren Fruiting Bodies
Abstract
1. Introduction
2. Materials and Methods
2.1. Strains and Growth Conditions
2.2. Mutagenesis
2.3. Identification of Genes Mutated in pfd3, pfd9, and vacua Mutants
2.4. Characterization of the Mutation in pfd23 Mutants
2.5. Phylogenetic Analysis
2.6. Deletion of mcm1 and ste12 Genes
2.7. Complementation of the pfd3, pfd9, pfd23, mcm1Δ, and vacua Mutants
2.8. Generation of the mcm1 Over-Expression Strains
2.9. Construction of the mcm1-GFP Strains
2.10. Growth and Development
2.11. Sensitivity to Various Stresses
3. Results
3.1. Mutant Recovery
3.2. Mutations
3.3. Deletion of mcm1 and Complementation
3.4. Sexual Development in the pfd Mutants and in mcm1Δ
3.5. Sensitivity to Various Stresses
3.6. Effects of Antifungals
3.7. Localization of MCM1
3.8. Interaction with vacua
3.9. Interaction with ste12
4. Discussion
5. Conclusions
Supplementary Materials
Author Contributions
Funding
Data Availability Statement
Acknowledgments
Conflicts of Interest
References
- Peraza-Reyes, L.; Berteaux-Lecellier, V. Peroxisomes and sexual development in fungi. Front. Physiol. 2013, 4, 244. [Google Scholar] [CrossRef] [PubMed]
- Silar, P. Simple Genetic Tools to Study Fruiting Body Development in Fungi. Open Mycol. J. 2014, 8, 148–155. [Google Scholar] [CrossRef]
- Dyer, P.S.; O'Gorman, C.M. Sexual development and cryptic sexuality in fungi: Insights from Aspergillus species. FEMS Microbiol. Rev. 2012, 36, 165–192. [Google Scholar] [CrossRef] [PubMed]
- Chinnici, J.L.; Fu, C.; Caccamise, L.M.; Arnold, J.W.; Free, S.J. Neurospora crassa Female Development Requires the PACC and Other Signal Transduction Pathways, Transcription Factors, Chromatin Remodeling, Cell-To-Cell Fusion, and Autophagy. PLoS ONE 2014, 9, e110603. [Google Scholar] [CrossRef] [PubMed][Green Version]
- Teichert, I.; Nowrousian, M.; Pöggeler, S.; Kück, U. The Filamentous Fungus Sordaria Macrospora as a Genetic Model to Study Fruiting Body Development. Adv. Genet. 2014, 87, 199–244. [Google Scholar] [CrossRef] [PubMed]
- Pöggeler, S.; Nowrousian, M.; Teichert, I.; Beier, A.; Kück, U. Fruiting-Body Development in Ascomycetes. In Physiology and Genetics: Selected Basic and Applied Aspects; Anke, T., Schüffler, A., Eds.; The Mycota; Springer International Publishing: Cham, Switzerland, 2018; pp. 1–56. ISBN 978-3-319-71740-1. [Google Scholar]
- Debuchy, R.; Berteaux-Lecellier, V.; Silar, P. Mating Systems and Sexual Morphogenesis in Ascomycetes. Cell. Mol. Biol. Filamentous Fungi 2010, 14, 501–535. [Google Scholar] [CrossRef]
- Nowrousian, M. Genomics and transcriptomics to study fruiting body development: An update. Fungal Biol. Rev. 2018, 32, 231–235. [Google Scholar] [CrossRef]
- Lütkenhaus, R.; Traeger, S.; Breuer, J.; Carreté, L.; Kuo, A.; Lipzen, A.; Pangilinan, J.; Dilworth, D.; Sandor, L.; Pöggeler, S.; et al. Comparative Genomics and Transcriptomics To Analyze Fruiting Body Development in Filamentous Ascomycetes. Genetics 2019, 213, 1545–1563. [Google Scholar] [CrossRef]
- Lalucque, H.; Malagnac, F.; Green, K.; Gautier, V.; Grognet, P.; Tong, L.C.H.; Scott, B.; Silar, P. IDC2 and IDC3, two genes involved in cell non-autonomous signaling of fruiting body development in the model fungus Podospora anserina. Dev. Biol. 2017, 421, 126–138. [Google Scholar] [CrossRef]
- Silar, P. Podospora anserina: From Laboratory to Biotechnology. In Genomics of Soil- and Plant-Associated Fungi; Horwitz, B.A., Mukherjee, P.K., Mukherjee, M., Kubicek, C.P., Eds.; Soil Biology; Springer: Berli/Heidelberg, Germany, 2013; pp. 283–309. ISBN 978-3-642-39338-9. [Google Scholar]
- Esser, K.; Graw, D. Homokaryotic Fruiting in the Bipolar-Incompatible Ascomycete Podospora anserina. Mycologia 1980, 72, 534–541. [Google Scholar] [CrossRef]
- Passmore, S.; Maine, G.T.; Elble, R.; Christ, C.; Tye, B.-K. Saccharomyces cerevisiae protein involved in plasmid maintenance is necessary for mating of MATα cells. J. Mol. Biol. 1988, 204, 593–606. [Google Scholar] [CrossRef] [PubMed]
- Passmore, S.; Elble, R.; Tye, B.K. A protein involved in minichromosome maintenance in yeast binds a transcriptional enhancer conserved in eukaryotes. Minerva Anestesiol. 1989, 3, 921–935. [Google Scholar] [CrossRef] [PubMed]
- Espagne, E.; Lespinet, O.; Malagnac, F.; Da Silva, C.; Jaillon, O.; Porcel, B.M.; Couloux, A.; Aury, J.-M.; Ségurens, B.; Poulain, J.; et al. The genome sequence of the model ascomycete fungus Podospora anserina. Genome Biol. 2008, 9, R77. [Google Scholar] [CrossRef] [PubMed]
- Silar, P. Podospora anserina. 2020. Available online: https://hal.archives-ouvertes.fr/hal-02475488 (accessed on 4 December 2023).
- El-Khoury, R.; Sellem, C.H.; Coppin, E.; Boivin, A.; Maas, M.F.P.M.; Debuchy, R.; Sainsard-Chanet, A. Gene deletion and allelic replacement in the filamentous fungus Podospora anserina. Curr. Genet. 2008, 53, 249–258. [Google Scholar] [CrossRef] [PubMed]
- Coppin, E.; Silar, P. Identification of PaPKS1, a polyketide synthase involved in melanin formation and its use as a genetic tool in Podospora anserina. Mycol. Res. 2007, 111, 901–908. [Google Scholar] [CrossRef] [PubMed]
- Grognet, P.; Bidard, F.; Kuchly, C.; Tong, L.C.H.; Coppin, E.; Benkhali, J.A.; Couloux, A.; Wincker, P.; Debuchy, R.; Silar, P. Maintaining Two Mating Types: Structure of the Mating Type Locus and Its Role in Heterokaryosis in Podospora anserina. Genetics 2014, 197, 421–432. [Google Scholar] [CrossRef] [PubMed]
- Langmead, B.; Salzberg, S.L. Fast gapped-read alignment with Bowtie 2. Nat. Methods 2012, 9, 357–359. [Google Scholar] [CrossRef]
- Li, H. Improving SNP discovery by base alignment quality. Bioinformatics 2011, 27, 1157–1158. [Google Scholar] [CrossRef]
- Koboldt, D.C.; Larson, D.E.; Wilson, R.K. Using VarScan 2 for Germline Variant Calling and Somatic Mutation Detection. Curr. Protoc. Bioinform. 2013, 44, 15.4.1–15.4.17. [Google Scholar] [CrossRef]
- Johnson, M.; Zaretskaya, I.; Raytselis, Y.; Merezhuk, Y.; McGinnis, S.; Madden, T.L. NCBI BLAST: A better web interface. Nucleic Acids Res. 2008, 36, W5–W9. [Google Scholar] [CrossRef]
- Grigoriev, I.V.; Nikitin, R.; Haridas, S.; Kuo, A.; Ohm, R.; Otillar, R.; Riley, R.; Salamov, A.; Zhao, X.; Korzeniewski, F.; et al. MycoCosm portal: Gearing up for 1000 fungal genomes. Nucleic Acids Res. 2013, 42, D699–D704. [Google Scholar] [CrossRef] [PubMed]
- Katoh, K.; Kuma, K.I.; Toh, H.; Miyata, T. MAFFT version 5: Improvement in accuracy of multiple sequence alignment. Nucleic Acids Res. 2005, 33, 511–518. [Google Scholar] [CrossRef] [PubMed]
- Waterhouse, A.M.; Procter, J.B.; Martin, D.M.A.; Clamp, M.; Barton, G.J. Jalview Version 2—A multiple sequence alignment editor and analysis workbench. Bioinformatics 2009, 25, 1189–1191. [Google Scholar] [CrossRef] [PubMed]
- Guindon, S.; Dufayard, J.-F.; Lefort, V.; Anisimova, M.; Hordijk, W.; Gascuel, O. New Algorithms and Methods to Estimate Maximum-Likelihood Phylogenies: Assessing the Performance of PhyML 3.0. Syst. Biol. 2010, 59, 307–321. [Google Scholar] [CrossRef]
- Letunic, I.; Bork, P. Interactive Tree Of Life (iTOL): An online tool for phylogenetic tree display and annotation. Bioinformatics 2007, 23, 127–128. [Google Scholar] [CrossRef] [PubMed]
- Lalucque, H.; Malagnac, F.; Brun, S.; Kicka, S.; Silar, P. A Non-Mendelian MAPK-Generated Hereditary Unit Controlled by a Second MAPK Pathway in Podospora anserina. Genetics 2012, 191, 419–433. [Google Scholar] [CrossRef] [PubMed]
- Bidard, F.; Benkhali, J.A.; Coppin, E.; Imbeaud, S.; Grognet, P.; Delacroix, H.; Debuchy, R. Genome-Wide Gene Expression Profiling of Fertilization Competent Mycelium in Opposite Mating Types in the Heterothallic Fungus Podospora anserina. PLoS ONE 2011, 6, e21476. [Google Scholar] [CrossRef]
- Coppin, E.; Berteaux-Lecellier, V.; Bidard, F.; Brun, S.; Ruprich-Robert, G.; Espagne, E.; Aït-Benkhali, J.; Goarin, A.; Nesseir, A.; Planamente, S.; et al. Systematic Deletion of Homeobox Genes in Podospora anserina Uncovers Their Roles in Shaping the Fruiting Body. PLoS ONE 2012, 7, e37488. [Google Scholar] [CrossRef]
- Silar, P. Two new easy to use vectors for transformations. Fungal Genet. Rep. 1995, 42, 73. [Google Scholar] [CrossRef]
- Tong, L.C.H.; Silar, P.; Lalucque, H. Genetic control of anastomosis in Podospora anserina. Fungal Genet. Biol. 2014, 70, 94–103. [Google Scholar] [CrossRef]
- Brun, S.; Malagnac, F.; Bidard, F.; Lalucque, H.; Silar, P. Functions and regulation of the Nox family in the filamentous fungus Podospora anserina: A new role in cellulose degradation. Mol. Microbiol. 2009, 74, 480–496. [Google Scholar] [CrossRef] [PubMed]
- Jamet-Vierny, C.; Debuchy, R.; Prigent, M.; Silar, P. IDC1, a Pezizomycotina-specific gene that belongs to the PaMpk1 MAP kinase transduction cascade of the filamentous fungus Podospora anserina. Fungal Genet. Biol. 2007, 44, 1219–1230. [Google Scholar] [CrossRef] [PubMed]
- Abraham, D.S.; Vershon, A.K. N-Terminal Arm of Mcm1 Is Required for Transcription of a Subset of Genes Involved in Maintenance of the Cell Wall. Eukaryot. Cell 2005, 4, 1808–1819. [Google Scholar] [CrossRef]
- Messenguy, F.; Dubois, E. Role of MADS Box Proteins and Their Cofactors in Combinatorial Control of Gene Ex-pression and Cell Development. Gene 2003, 316, 1–21. [Google Scholar] [CrossRef] [PubMed]
- Ojeda-López, M.; Chen, W.; Eagle, C.E.; Gutiérrez, G.; Jia, W.L.; Swilaiman, S.S.; Huang, Z.; Park, H.-S.; Yu, J.-H.; Cánovas, D.; et al. Evolution of asexual and sexual reproduction in the Aspergilli. Stud. Mycol. 2018, 91, 37–59. [Google Scholar] [CrossRef]
- Nolting, N.; Pöggeler, S. A STE12 homologue of the homothallic ascomycete Sordaria macrospora interacts with the MADS box protein MCM1 and is required for ascosporogenesis. Mol. Microbiol. 2006, 62, 853–868. [Google Scholar] [CrossRef]
- Tharreau, D.; Notteghem, J.-L.; Lebrun, M.-H. Mutations Affecting Perithecium Development and Sporulation in Magnaporthe grisea. Fungal Genet. Biol. 1997, 21, 206–213. [Google Scholar] [CrossRef]
- Dubois, E.; Bercy, J.; Messenguy, F. Characterization of two genes, ARGRI and ARGRIII required for specific regulation of arginine metabolism in yeast. Mol. Genet. Genom. 1987, 207, 142–148. [Google Scholar] [CrossRef]
- Yanofsky, M.F.; Ma, H.; Bowman, J.L.; Drews, G.N.; Feldmann, K.A.; Meyerowitz, E.M. The protein encoded by the Arabidopsis homeotic gene agamous resembles transcription factors. Nature 1990, 346, 35–39. [Google Scholar] [CrossRef]
- Sommer, H.; Beltrán, J.P.; Huijser, P.; Pape, H.; Lönnig, W.E.; Saedler, H.; Schwarz-Sommer, Z. Deficiens, a Homeotic Gene Involved in the Control of Flower Morphogenesis in Antirrhinum majus: The Protein Shows Homology to Transcrip-tion Factors. EMBO J. 1990, 9, 605–613. [Google Scholar] [CrossRef]
- Norman, C.; Runswick, M.; Pollock, R.; Treisman, R. Isolation and properties of cDNA clones encoding SRF, a transcription factor that binds to the c-fos serum response element. Cell 1988, 55, 989–1003. [Google Scholar] [CrossRef] [PubMed]
- Shore, P.; Sharrocks, A.D. The MADS-Box Family of Transcription Factors. Eur. J. Biochem. 1995, 229, 1–13. [Google Scholar] [CrossRef] [PubMed]
- Bastajian, N.; Friesen, H.; Andrews, B.J. Bck2 Acts through the MADS Box Protein Mcm1 to Activate Cell-Cycle-Regulated Genes in Budding Yeast. PLoS Genet. 2013, 9, e1003507. [Google Scholar] [CrossRef] [PubMed]
- Nolting, N.; Pöggeler, S. A MADS Box Protein Interacts with a Mating-Type Protein and Is Required for Fruiting Body Development in the Homothallic Ascomycete Sordaria macrospora. Eukaryot. Cell 2006, 5, 1043–1056. [Google Scholar] [CrossRef] [PubMed]
- Elleuche, S.; Bernhards, Y.; Schäfers, C.; Varghese, J.M.; Nolting, N.; Pöggeler, S. The small serine-threonine protein SIP2 interacts with STE12 and is involved in ascospore germination in Sordaria macrospora. Eur. J. Cell Biol. 2010, 89, 873–887. [Google Scholar] [CrossRef] [PubMed]
- Li, N.; Kunitake, E.; Endo, Y.; Aoyama, M.; Kanamaru, K.; Kimura, M.; Kato, M.; Kobayashi, T. Involvement of an SRF-MADS protein McmA in regulation of extracellular enzyme production and asexual/sexual development in Aspergillus nidulans. Biosci. Biotechnol. Biochem. 2016, 80, 1820–1828. [Google Scholar] [CrossRef] [PubMed]
- Yang, C.; Liu, H.; Li, G.; Liu, M.; Yun, Y.; Wang, C.; Ma, Z.; Xu, J. The MADS-box transcription factor FgMcm1 regulates cell identity and fungal development in Fusarium graminearum. Environ. Microbiol. 2015, 17, 2762–2776. [Google Scholar] [CrossRef]
- Liu, W.; Han, L.; Chen, J.; Liang, X.; Wang, B.; Gleason, M.L.; Zhang, R.; Sun, G. The CfMcm1 Regulates Pathogenicity, Conidium Germination, and Sexual Development in Colletotrichum fructicola. Phytopathology® 2022, 112, 2159–2173. [Google Scholar] [CrossRef]
- Zhou, X.; Liu, W.; Wang, C.; Xu, Q.; Wang, Y.; Ding, S.; Xu, J. A MADS-box transcription factor MoMcm1 is required for male fertility, microconidium production and virulence in Magnaporthe oryzae. Mol. Microbiol. 2011, 80, 33–53. [Google Scholar] [CrossRef]
- Zhao, X.; Yang, X.; Lu, Z.; Wang, H.; He, Z.; Zhou, G.; Luo, Z.; Zhang, Y. MADS-box transcription factor Mcm1 controls cell cycle, fungal development, cell integrity and virulence in the filamentous insect pathogenic fungus Beauveria bassiana. Environ. Microbiol. 2018, 21, 3392–3416. [Google Scholar] [CrossRef]
- Xiong, D.; Wang, Y.; Tian, L.; Tian, C. MADS-Box Transcription Factor VdMcm1 Regulates Conidiation, Microsclerotia Formation, Pathogenicity, and Secondary Metabolism of Verticillium dahliae. Front. Microbiol. 2016, 7, 1192. [Google Scholar] [CrossRef]
- Chou, S.; Lane, S.; Liu, H. Regulation of Mating and Filamentation Genes by Two Distinct Ste12 Complexes in Saccharomyces cerevisiae. Mol. Cells Biol. 2006, 26, 4794–4805. [Google Scholar] [CrossRef]
- Vallim, M.A.; Miller, K.Y.; Miller, B.L. Aspergillus stea (Sterile12-like) is a homeodomain-C2/H2-Zn+2 finger transcription factor required for sexual reproduction. Mol. Microbiol. 2000, 36, 290–301. [Google Scholar] [CrossRef]
- Li, D.; Bobrowicz, P.; Wilkinson, H.H.; Ebbole, D.J. A Mitogen-Activated Protein Kinase Pathway Essential for Mating and Contributing to Vegetative Growth in Neurospora crassa. Genetics 2005, 170, 1091–1104. [Google Scholar] [CrossRef]
- Park, G.; Xue, C.; Zheng, L.; Lam, S.; Xu, J.-R. MST12 Regulates Infectious Growth But Not Appressorium Formation in the Rice Blast Fungus Magnaporthe grisea. Mol. Plant-Microbe Interact. 2002, 15, 183–192. [Google Scholar] [CrossRef] [PubMed]
- Kim, H.-J.; Han, J.-H.; Kim, K.S.; Lee, Y.-H. Comparative functional analysis of the velvet gene family reveals unique roles in fungal development and pathogenicity in Magnaporthe oryzae. Fungal Genet. Biol. 2014, 66, 33–43. [Google Scholar] [CrossRef] [PubMed]
- Park, H.-S.; Nam, T.-Y.; Han, K.-H.; Kim, S.C.; Yu, J.-H. VelC Positively Controls Sexual Development in Aspergillus nidulans. PLoS ONE 2014, 9, e89883. [Google Scholar] [CrossRef] [PubMed]
- Bayram, S.; Dettmann, A.; Karahoda, B.; Moloney, N.M.; Ormsby, T.; McGowan, J.; Cea-Sánchez, S.; Miralles-Durán, A.; Brancini, G.T.P.; Luque, E.M.; et al. Control of Development, Secondary Metabolism and Light-Dependent Carotenoid Biosynthesis by the Velvet Complex of Neurospora crassa. Genetics 2019, 212, 691–710. [Google Scholar] [CrossRef] [PubMed]
- Kuo, M.-H.; Nadeau, E.T.; Grayhack, E.J. Multiple Phosphorylated Forms of the Saccharomyces cerevisiae Mcm1 Protein Include an Isoform Induced in Response to High Salt Concentrations. Mol. Cells Biol. 1997, 17, 819–832. [Google Scholar] [CrossRef] [PubMed]
- Contamine, V.; Zickler, D.; Picard, M. The Podospora rmp1 Gene Implicated in Nucleus-Mitochondria Cross-Talk Encodes an Essential Protein Whose Subcellular Location Is Developmentally Regulated. Genetics 2004, 166, 135–150. [Google Scholar] [CrossRef] [PubMed][Green Version]
- Mogavero, S.; Tavanti, A.; Senesi, S.; Rogers, P.D.; Morschhäuser, J. Differential Requirement of the Transcription Factor Mcm1 for Activation of the Candida albicans Multidrug Efflux Pump MDR1 by Its Regulators Mrr1 and Cap1. Antimicrob. Agents Chemother. 2011, 55, 2061–2066. [Google Scholar] [CrossRef]

| Mutant | Fruiting Body Formation | Linkage | Other Phenotypes | |
|---|---|---|---|---|
| Mutagenesis I | pfd1 | Large neckless protoperithecia | Fluffy | |
| pfd3 mat- | Normal-looking perithecia when in heterokaryon with the wild type of same mating type | mat (d < 1 cM) | Flat and dark mycelium, male sterility, female sterility but small protoperithecia formed | |
| pfd4 | Large neckless protoperithecia | Spindly mycelium that becomes wild type, homozygous crosses produce empty perithecia filled with jelly | ||
| pfd6 | Large neckless protoperithecia | Fluffy | ||
| pfd7 | Large neckless protoperithecia | Fluffy | ||
| pfd8 | Large neckless protoperithecia | None | ||
| pfd9 mat- | Normal-looking perithecia and large neckless protoperithecia | mat (d < 1 cM) | None | |
| pfd10 | Large protoperithecia some with neck initials | Slow and fluffy growth, homozygous crosses are partially sterile | ||
| pfd11 | Large neckless protoperithecia | Pink mycelium, homozygous crosses are sterile | ||
| pfd12 | Large neckless protoperithecia | Pink mycelium, homozygous crosses are sterile | ||
| pfd13 | Few normal-looking perithecia and large neckless protoperithecia | Homozygous crosses are sterile | ||
| pfd15 | Large neckless protoperithecia | None | ||
| pfd16 | Large neckless protoperithecia | Pink mycelium, homozygous crosses are partially sterile | ||
| pfd17 | Few normal-looking perithecia and large neckless protoperithecia | Fluffy, perithecia with abnormally shaped neck in homozygous crosses | ||
| Mutagenesis II | pdf18 | Large neckless protoperithecia | None | |
| pfd19 | Few normal-looking perithecia and large neckless protoperithecia | Fluffy, perithecia with abnormally shaped neck in homozygous crosses | ||
| pfd20 | Large neckless protoperithecia | Fluffy | ||
| pfd21 | Large neckless protoperithecia | None | ||
| pfd22 | Large neckless protoperithecia | None | ||
| pfd23 mat+ | Normal-looking perithecia and large neckless protoperithecia | mat (d < 1 cM) | Dark and fluffy mycelium | |
| pfd24 | Large neckless protoperithecia | None | ||
| pfd25 | Large neckless protoperithecia | None | ||
| pfd26 | Large neckless protoperithecia | None | ||
| pfd28 | Large neckless protoperithecia | Pink mycelium | ||
| pfd29 | Large neckless protoperithecia | None | ||
| pfd30 | Small perithecia with large necks | Slow-growing mycelium | ||
| pfd31 | Few normal-looking perithecia and large neckless protoperithecia | None |
| Strains | MIC Fluconazole | MIC Itraconazole | MIC Amphotericin B |
|---|---|---|---|
| S | 6 µg/µL | 0.5 µg/µL | 0.047 µg/µL |
| mcm1∆ | 16 µg/µL | 2 µg/µL | 0.032 µg/µL |
| pfd3 | 12 µg/µL | 1.5 µg/µL | 0.032 µg/µL |
| pfd9 | 16 µg/µL | 1.0 µg/µL | 0.19 µg/µL |
| pfd23 | >256 µg/µL | >32 µg/µL | 0.25 µg/µL |
Disclaimer/Publisher’s Note: The statements, opinions and data contained in all publications are solely those of the individual author(s) and contributor(s) and not of MDPI and/or the editor(s). MDPI and/or the editor(s) disclaim responsibility for any injury to people or property resulting from any ideas, methods, instructions or products referred to in the content. |
© 2024 by the authors. Licensee MDPI, Basel, Switzerland. This article is an open access article distributed under the terms and conditions of the Creative Commons Attribution (CC BY) license (https://creativecommons.org/licenses/by/4.0/).
Share and Cite
Essadik, I.; Boucher, C.; Bobée, C.; Cabet, É.; Gautier, V.; Lalucque, H.; Silar, P.; Chapeland-Leclerc, F.; Ruprich-Robert, G. Mutations in Podospora anserina MCM1 and VelC Trigger Spontaneous Development of Barren Fruiting Bodies. J. Fungi 2024, 10, 79. https://doi.org/10.3390/jof10010079
Essadik I, Boucher C, Bobée C, Cabet É, Gautier V, Lalucque H, Silar P, Chapeland-Leclerc F, Ruprich-Robert G. Mutations in Podospora anserina MCM1 and VelC Trigger Spontaneous Development of Barren Fruiting Bodies. Journal of Fungi. 2024; 10(1):79. https://doi.org/10.3390/jof10010079
Chicago/Turabian StyleEssadik, Insaf, Charlie Boucher, Cécilia Bobée, Éva Cabet, Valérie Gautier, Hervé Lalucque, Philippe Silar, Florence Chapeland-Leclerc, and Gwenaël Ruprich-Robert. 2024. "Mutations in Podospora anserina MCM1 and VelC Trigger Spontaneous Development of Barren Fruiting Bodies" Journal of Fungi 10, no. 1: 79. https://doi.org/10.3390/jof10010079
APA StyleEssadik, I., Boucher, C., Bobée, C., Cabet, É., Gautier, V., Lalucque, H., Silar, P., Chapeland-Leclerc, F., & Ruprich-Robert, G. (2024). Mutations in Podospora anserina MCM1 and VelC Trigger Spontaneous Development of Barren Fruiting Bodies. Journal of Fungi, 10(1), 79. https://doi.org/10.3390/jof10010079

